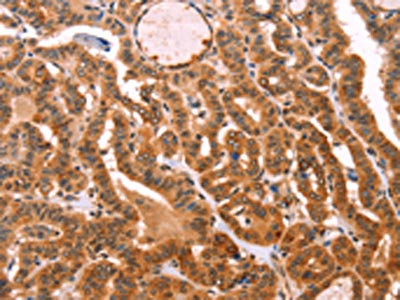

PROS1 Antibody
-
中文名稱:PROS1兔多克隆抗體
-
貨號:CSB-PA121719
-
規格:¥1100
-
圖片:
-
The image on the left is immunohistochemistry of paraffin-embedded Human thyroid cancer tissue using CSB-PA121719(PROS1 Antibody) at dilution 1/40, on the right is treated with fusion protein. (Original magnification: ×200)
-
The image on the left is immunohistochemistry of paraffin-embedded Human lung cancer tissue using CSB-PA121719(PROS1 Antibody) at dilution 1/40, on the right is treated with fusion protein. (Original magnification: ×200)
-
-
其他:
產品詳情
-
Uniprot No.:
-
基因名:
-
別名:Preproprotein S antibody; Propiece of latent protein S antibody; PROS 1 antibody; PROS antibody; PROS_HUMAN antibody; proS1 antibody; Protein S alpha antibody; Protein Sa antibody; PS 21 antibody; PS 22 antibody; PS 23 antibody; PS 24 antibody; PS 25 antibody; PS 26 antibody; PS21 antibody; PS22 antibody; PS23 antibody; PS24 antibody; PS25 antibody; PS26 antibody; PSA antibody; THPH5 antibody; THPH6 antibody; Vitamin K dependent protein S antibody; Vitamin K-dependent plasma protein S antibody; Vitamin K-dependent protein S antibody
-
宿主:Rabbit
-
反應種屬:Human
-
免疫原:Fusion protein of Human PROS1
-
免疫原種屬:Homo sapiens (Human)
-
標記方式:Non-conjugated
-
抗體亞型:IgG
-
純化方式:Antigen affinity purification
-
濃度:It differs from different batches. Please contact us to confirm it.
-
保存緩沖液:-20°C, pH7.4 PBS, 0.05% NaN3, 40% Glycerol
-
產品提供形式:Liquid
-
應用范圍:ELISA,IHC
-
推薦稀釋比:
Application Recommended Dilution ELISA 1:2000-1:10000 IHC 1:50-1:200 -
Protocols:
-
儲存條件:Upon receipt, store at -20°C or -80°C. Avoid repeated freeze.
-
貨期:Basically, we can dispatch the products out in 1-3 working days after receiving your orders. Delivery time maybe differs from different purchasing way or location, please kindly consult your local distributors for specific delivery time.
-
用途:For Research Use Only. Not for use in diagnostic or therapeutic procedures.
相關產品
靶點詳情
-
功能:Anticoagulant plasma protein; it is a cofactor to activated protein C in the degradation of coagulation factors Va and VIIIa. It helps to prevent coagulation and stimulating fibrinolysis.
-
基因功能參考文獻:
- The authors provide strong evidence that the rare Protein S Heerlen (PSH) mutation variant is associated with venous thrombosis in unselected individuals. PMID: 28374852
- Functional PROS1 variants are more common in the general Swedish population than anticipated. PMID: 29883906
- The present case combined with the review of the literature suggests that p.Arg451* in the PROS1 gene mainly leads to clinically evident thrombosis following trauma, surgery or serious comorbidities especially malignancy. PMID: 29321366
- Protein S and Gas6 mediates phagocytosis of HIV-1-infected cells by bridging receptor tyrosine kinase Mer to phosphatidylserine exposed on infected cells. PMID: 29304470
- these results suggest a novel pathogenic role of SPE B that initiates protein S degradation followed by the inhibition of apoptotic cell clearance by macrophages PMID: 27181595
- Taken together, our gain-of-function, loss-of-function analyses suggest that PROS may facilitate cell proliferation and promote castration resistance in human castration-resistant PCa-like cells via its apoptosis-regulating property. PMID: 27342144
- protein S has a clinical relevance and a protective role in pulmonary fibrosis PMID: 27172994
- Due to the versatility exemplified, this probe holds great promise for exploring the role of protein S-nitrosylation in the pathophysiological process of a variety of vascular diseases PMID: 28284075
- There was no association between PS-Tokushima and recurrent pregnancy loss and a PS deficiency or low PS activity was shown not to serve as a reliable clinical predictor of subsequent miscarriage. PMID: 28214760
- we identify PROS1 as a driver of Oral Squamous Cell Carcinoma tumor growth and a modulator of AXL expression PMID: 28118606
- The prevalence of PS de fi ciency in the present study was higher than in Western countries and con fi rms the high prevalence of PS de fi ciency in Asian populations PMID: 27748013
- Patients with type 2 diabetes had significantly lower circulating free protein S than healthy control subjects PMID: 27207541
- In the present study, gene analysis of six unrelated Japanese families diagnosed with congenital protein S deficiency identified five missense mutations in the PROS1 gene - c.757C>T (Ala139Val; A139V), c.1346 G>T (Cys449Phe; C449F), c.1352G>A (Arg451Gln; R451Q), c.1424G>T (Cys475Phe; C475F) and c.1574C>T (Ala525Val; A525V) - and one frameshift mutation, c.2135delA (Asp599ThrfsTer13; D599TfsTer13). PMID: 28088608
- The odds ratio of developing idiopathic fatal pulmonary embolism as a variant carrier for PROS1 is 56.4 (95% CI, 5.3-351.1; P = 0.001). PMID: 28174134
- described a novel PROS1 frameshift mutation, c.74dupA, in a hereditary protein S deficiency family. Interestingly, both of the proband and his mother carried the mutation and had a protein S deficiency, however, only the proband suffered a pulmonary embolism while his mother had no history of any thrombosis, suggesting that a triggering event might have been involved in the thrombus formation. PMID: 27846449
- PROS1 may play an important role in the development of glioblastoma multiforme through cellular proliferation, migration and invasion as well as apoptosis. PMID: 27840905
- Low protein S expression is associated with diabetes mellitus. PMID: 27345772
- analysis of genotype phenotype correlation in PROS1 in a large cohort of adults with suspicion of inherited quantitative protein S deficiency PMID: 26466767
- The immunoabsorption of PON1 from plasma significantly reduced protein S anti-coagulant activity. PMID: 26358807
- Elevated levels of circulating microparticles can play a role in carriers of mild and severe inherited thrombophilia resulting from protein S deficiency. PMID: 26354831
- The ELISA system using the PS K196E mutation-specific antibody is a useful tool for the rapid identification of PS K196E carriers, who are at a higher risk for venous thromboembolism. PMID: 26186226
- A PROS1 c.1486_1490delGATTA mutation on exon 12. appeared to be the primary cause of thrombosis in the family of the present study. PMID: 25997409
- analysis of the amino acid residues in the laminin G domains of protein S involved in tissue factor pathway inhibitor interaction PMID: 25716664
- Women with low levels of plasma PS activity and free PS during early pregnancy might have increased risks of pregnancy-induced hypertension, or pre-eclampsia. PMID: 25879167
- analysis of compound heterozygote protein S deficiency in two Japanese patients [case reports] PMID: 25868595
- Protein S exacerbates acute alcoholic hepatitis by inhibiting apoptosis of activated natural killer T cells. PMID: 25399514
- The present study highlights that the GAS6/ProS-TAM system correlates in several ways with disease activity in systemic lupus erythematosus PMID: 23497733
- genetic polymorphism affects endogenous thrombin potential among FV Leiden carriers PMID: 24226152
- Identical large duplication mutation of PROS1 was detected in 3 unrelated patients with thrombophilia from hereditary protein S deficiency. PMID: 24992033
- Anti-human protein S antibody induces tissue factor expression through a direct interaction with PFKP and ERK1/2 activation in coronary artery endothelial cells. PMID: 24331211
- Data indicate that the protein S sex hormone-binding globulin (SHBG)-like domain was important for binding and enhancement of tissue factor pathway inhibitor (TFPI). PMID: 24740810
- study found the S K196E mutation, a genetic risk factor for venous thromboembolism, was not found in Chinese or Koreans; results suggest the protein S K196E mutation is a recent occurrence and fixed within the Japanese population PMID: 23721692
- implicate protein S residues 37-50 as a binding site for FVa that mediates, at least in part, the direct inhibition of FVa-dependent procoagulant activity by protein S PMID: 23892573
- miR-494 is involved in the mechanism of estrogen-mediated downregulation of PS expression PMID: 23789915
- This is the first report of a large deletion of PROS1 from exon 1 through 12 in Polish patients with deep-vein thrombosis. PMID: 23473639
- PS exerts anticoagulant cofactor activity with TFPIalpha from any physiological pool, likely by localizing TFPIalpha to membrane surfaces, stabilizing its interaction with membrane-bound FXa, and slowing thrombin generation. PMID: 24233490
- Data suggest that protein S testing and PROS1 testing should not be considered in unselected patients with venous thrombosis. PMID: 24014240
- This study is the largest investigation of ProS deficiency in China and the first investigation of the influence of Type I ProS missense mutations on the global level of coagulation function. PMID: 23813890
- The effect of oral contraceptives on TFPI and PS is a possible explanation for the increased risk of venous thrombosis associated with oral contraceptives. PMID: 23407778
- Data indicate that activated T cells express Pros1. PMID: 23850380
- Platelet protein S may be an essential pool of protein S that counterbalances procoagulant activities on platelets. PMID: 23238804
- sputum glutaredoxin-1 may have a role in asthma, while protein S may have a role in better lung function PMID: 23370801
- The tyrosine kinase receptor MER is activated by PROS and mediates its inhibitory effect on VEGF-A-induced EC proliferation. PMID: 23065156
- TFPI Kunitz domain 3 residue Glu226 is essential for TFPI enhancement by protein S. PMID: 23074276
- PROS1 is elevated in high grade and castration-resistant prostate cancer and could serve as a potential biomarker of aggressive disease. PMID: 22908226
- mutation deletions but no other types of rearrangements detected in patients with protein S deficiency PMID: 22627709
- genetic polymorphism is associated with increased free plasma tissue factor pathway inhibitor levels PMID: 22273984
- proteolytic cleavage is increased in patients with essential thrombocythaemia and reduced in patients with chemotherapy-induced thrombocytopenia PMID: 22318644
- Serum of women during third trimester of pregnancy complicated by intrauterine growth restriction (IUGR) had significantly lower functional and free protein S compared with control; however, no correlation was found between total protein S and IUGR. PMID: 22104477
- Persistently low protein S activity levels are highly indicative of a genetic alteration in PROS1. PMID: 22261441
顯示更多
收起更多
-
相關疾病:Thrombophilia due to protein S deficiency, autosomal dominant (THPH5); Thrombophilia due to protein S deficiency, autosomal recessive (THPH6)
-
亞細胞定位:Secreted.
-
組織特異性:Plasma.
-
數據庫鏈接:
Most popular with customers
-
Phospho-YAP1 (S127) Recombinant Monoclonal Antibody
Applications: ELISA, WB, IHC
Species Reactivity: Human
-
-
-
-
-
-
-
VCP Recombinant Monoclonal Antibody
Applications: ELISA, WB, IHC, IF, IP
Species Reactivity: Human, Rat